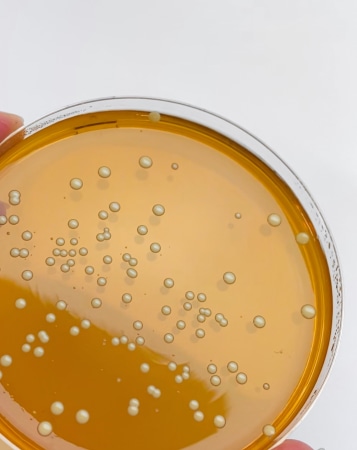
Explore jobs at YUN - team picture

YUN
Niel
Chemistry, biotechnology & pharmacy
About YUN
Je komt terecht in een knaller van biotechnologische start-up met ambities waar Elon Musk zelfs een beetje bleek wordt. Vanuit bergen theorie ontstond onze probiotherapie: in plaats van alle huidbacteriën te doden, voegen we miljoenen goede levende bacteriën toe die huidproblemen snel en effectief aanpakken. Ons kantoor in Niel is niet het centrum van ’t Stad of de rustige boerenbuiten, maar met het brouwerijcafé achter de hoek en een oase van...
Read more
These companies might interest you!
We've listed everything for you
Jobs, internships, student jobs or student rooms all over Belgium. Choose your city.
Employers
Discover our servicesPricing for job postingsFor startupsPublish a vacancyNews for employersGet in touchSchools & universities
Supporting students togetherGet in touchJob fairs and events
Jobday Sciences ULB-VUBJobfair Engineers ULBLocal' Job Fair ALIFUCaMSolvay Startup WorldBusiness school fair